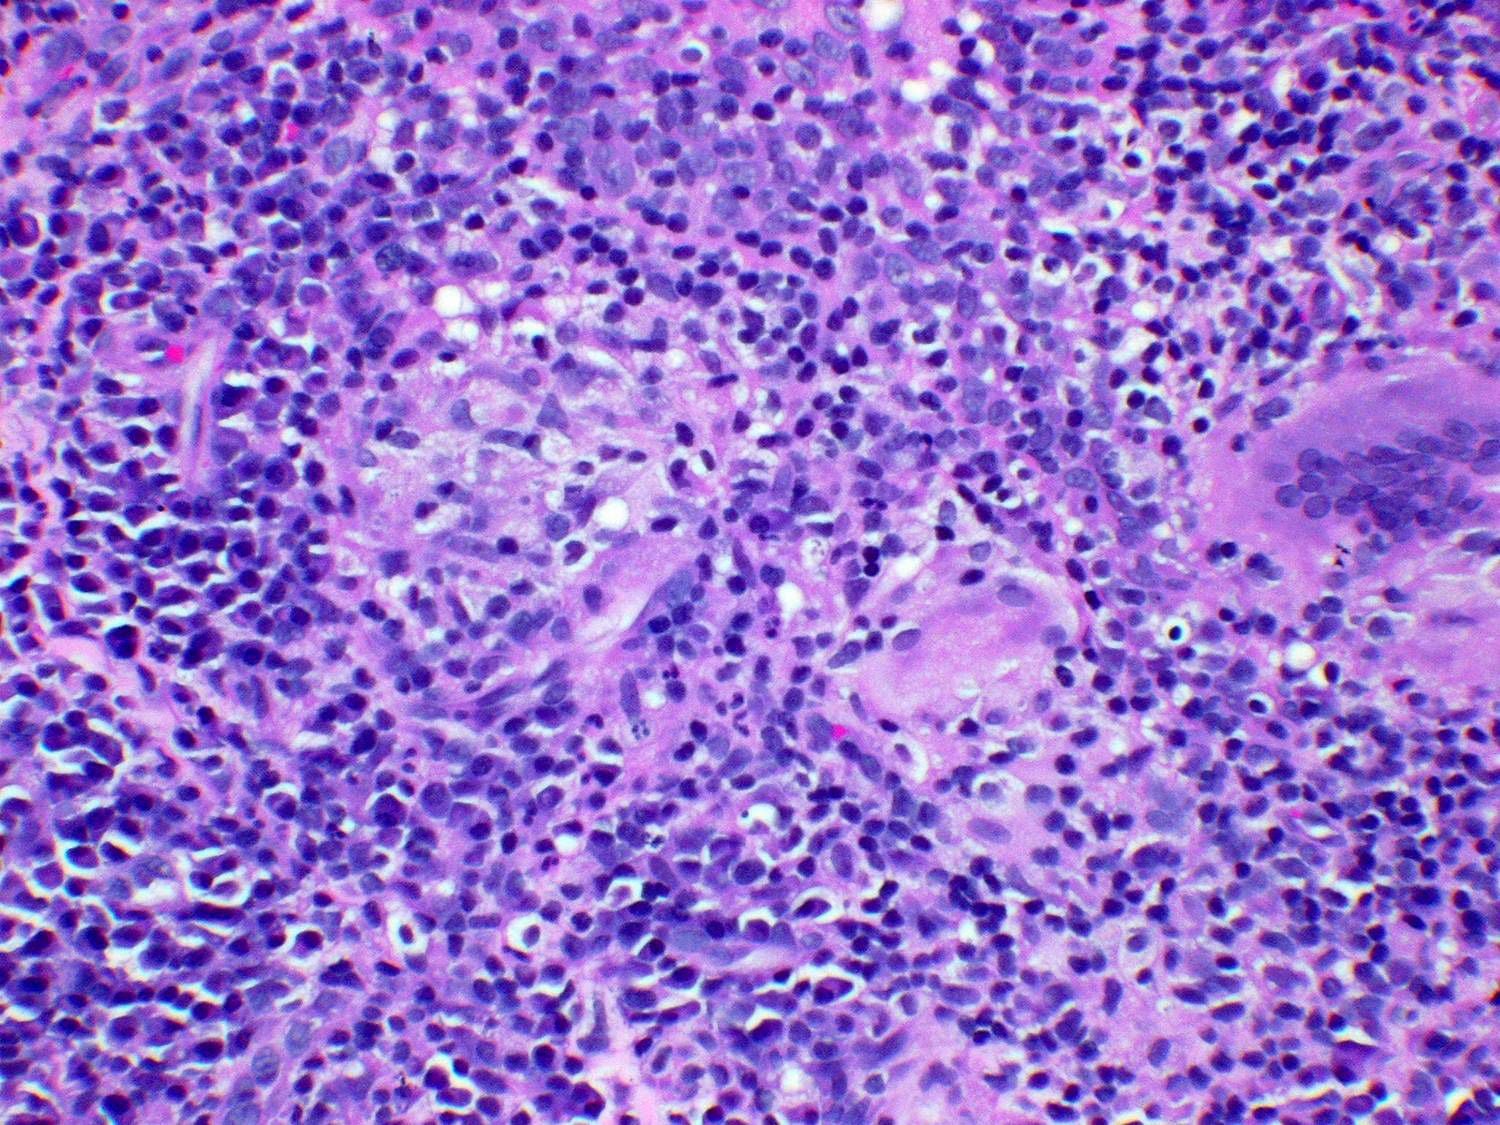

Csecsemő- és kisgyermekkorban a bélbetüremkedés a bélelzáródás leggyakoribb formája. Bélbetüremkedés akkor keletkezik, ha a vékonybél egy szakasza – akárcsak a kifordított kesztyű ujja – bepréselődik az előtte lévő bélbe. Ez a „megkettőződött” bél megduzzad, az erek elszorítódnak és ez bélelzáródást is okozhat. A bélbetüremkedést kiváltó okot nem ismerjük, annyi azonban bizonyos, hogy leggyakrabban egyévesnél fiatalabb, s mindaddig kitűnő egészségnek örvendő csecsemőket támad meg. Az izomgörcsök kezdetekor a kisbaba hirtelen, fájdalmasan felsír, hány, elsápad. A görcsök közötti időszakban teljesen egészségesnek látszik, az első néhány órában a széklete is normális még. A görcsök kiújulásával azonban a széklet sok vért és nyálkát tartalmaz.Súlyosnak tekinthető-e?A bélbetüremkedés súlyos állapot. Ha nem kezelik, végzetes lehet.Mi a teendő?Forduljunk azonnal orvoshoz, ha a csecsemő görcsös rohamai visszatérnek, ilyenkor fájdalmasan felsír, felkapja a lábát, a rohamok között viszont jól érzi magát.Ellenőrizze csecsemője székletét: van-e benne vér és nyálka.Mikor forduljunk orvoshoz?Forduljunk azonnal orvoshoz, ha a kisbabának gyakran van rohamszerű hasgörcse, vagy ha véres, nyálkás a széklete.Mit várhatunk az orvostól?• Az orvos kórházba utalja a csecsemőt, ahol feltöltéses röntgenvizsgálattal erősítik meg a diagnózist. A vizsgálat nem jár fájdalommal, végbélen keresztül folyadékot töltenek a belekbe, az ezt követő röntgenfelvétel megmutatja a belek állapotát. Az is előfordulhat, hogy a beöntés hatására a bélbetüremkedés magától rendbe jön. Ellenkező esetben műtéti úton nyomják vissza eredeti helyzetébe.Tünetek• Fájdalmas felsírás.• Hányás.• Sápadtság.• Hőemelkedés.• Vért és nyálkát tartalmazó széklet.
Hozzászólások (0)
Jelentkezz be, hogy hozzászólhass!
BejelentkezésMég nincs hozzászólás.
Legyél az első, aki hozzászól!
